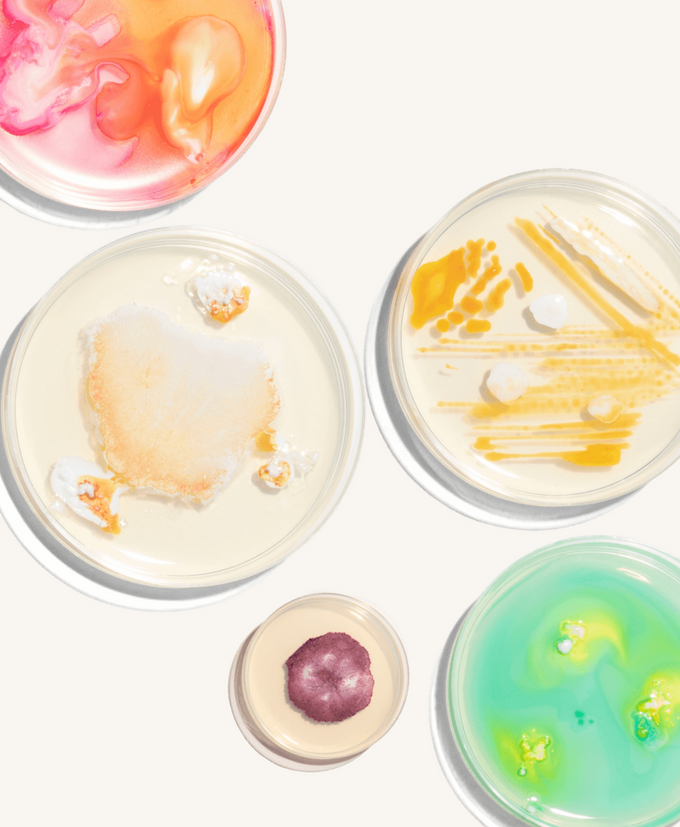

Biotic⁺

Got a discount code? Add it in the next step.
4.8/5 based on 8,925 reviews
Voted overall #1 product for sleep, magnesium, multivitamin and electrolyte drink
I was less inclined to doomscroll and felt more productive.
A proven, high-impact formula.
Thanks to its smart packaging, the formula stays in tip-top shape for longer.
The best super supplements to take!
Our supplements are scientifically proven to work, using only the highest-impact ingredients.
The result? Over 120,000 happy customers feeling their best.
Formulated by
scientists
2,100+ scientific
studies
Smarter capsule
technology
Third-party
tested
From sleep to daily nutrition and hydration, our products have been voted best-in-class by GQ.
Discover our award-winning supplements, leading the way to help you feel your best, every day.

 20 nutrients
20 nutrients
20 key nutrients to fuel your body and feed your brain
 20 billion CFU
20 billion CFU
7 high-impact bacteria strains + zinc, proven to go further
 Magnesium glycinate
Magnesium glycinate
Magnesium glycinate to power 300+ bodily functions
 Botanical blend
Botanical blend
A botanical blend to help you reset and feel balanced
Our supplements are packed with the most effective ingredients out there, and nothing else.

In a 12-week third-party study, Vitals⁺ improved sleep by an average of 1 extra hour per night, supporting deeper rest.
Participants also reported a 33% drop in fatigue and less confusion, boosting daily energy and productivity.
On average, Vitals⁺ improved working memory by 54%, helping participants feel sharper.
In blood tests, after 12 weeks of taking Vitals⁺, participants had 25% lower cortisol levels, helping them feel more resilient.
Under SHIME® testing, replicating the upper digestive tract Biotic⁺’s delayed-release capsules delivered over 50x more live bacteria than standard probiotics.
In a placebo-controlled study, after 8 weeks 100% of people maintained or increased their microbial diversity – a key marker of a stronger microbiome.
In our placebo-controlled trial, after 8 weeks 73% of participants reported an improvement in daily mood.
From dietitians to neuroscientists, we work with leading minds and experienced researchers at the very top of their game.
So you can be at yours.
PhD
Science Advisor
RD
Head of Nutritional Research
PhD
Head of Science & Research / Heights
Physiologist
Chief Wellbeing Officer / Heights
PhD, RD, BSc
Professor of Nutrition and Dietetics | Ulster University
BSc, PhD, DSC
Professor of Applied Physiology | University of Exeter
PhD, MSc, FRSC, CChem, CSci
Consultant Clinical Scientist & Honorary Senior Clinical Lecturer / Synnovis, St Thomas' Hospital
MBBS (Hons), MPH, MD, DNHE, RNutr
Professor of Global Nutrition & NNEdPro Chief Scientist
PhD, BSc
Professor of Nutrigenetics| UEA Medical School
GLUTEN
GMOs
DAIRY
ANIMAL BY-PRODUCTS
FILLERS
ALLERGENS
CONTAMINANTS
SUGAR
ADDITIVES
TOXINS
HEAVY METALS
I hope I'm smart enough to know that excessive claims are silly, but I can certainly say with all truth that taking Heights has coincided with me feeling uncommonly fresh, perky, and lively in the mind. I'm a huge fan of it!
I feel like I've found a very simple solution that keeps me energised and balanced, and ready to tackle whatever the day brings. I know I'm giving my body everything it needs so I can perform at my best, day-in-day-out.
I used to take 20 supplements a day. No lie. And now I take 3. I instantly felt more cognitive, like my brain worked better, and I felt like I was focused throughout the day. I woke up not feeling tired. I woke up ready to go. The only thing I was doing differently was Heights.
As a busy mum, I’m always keeping my eyes peeled for good-value ways to look after myself and my family. If you want the complete package, the bundle from Heights—Vitals⁺ and Biotic⁺—is so easy, and helps me be my best self.
People don't understand that having a healthy gut can help give you a healthy body. It improves the function of your mind, to your work, to your relationships. It's so important. And I finally found the perfect answer—Biotic⁺ by Heights.
One thing I know is high quality supplements, as I've been selecting only the best for our stores from the start. Heights is so good I've bought 5 subscriptions - my family are all fans and you should be too.
By taking 2 every morning, you get all of the essential nutrients you need without having to deal with drinking sludge.
Because good choices should come with great perks.
Cancel, skip or add products. Without the obstacle course.
Not for you? No problem. Just reach out for a refund.
Give 20% off and get 20% off when you refer a friend.